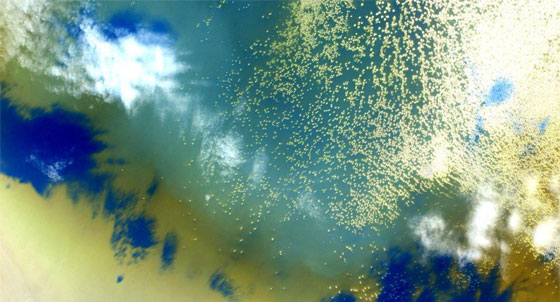
الارض في عام من الصور والحكايات.. كما عاشها الفضائي كيلي صورة رقم 5

بعد عام كامل في الفضاء، عاد رائد الفضاء الأميركي سكوت كيلي إلى الأرض، وفي جعبته صور وحكايات يرويها لنا عن أرضنا والحالات التي مرت بها خلال ذلك الوقت، منها الجميل ومنها الغريب. ومنذ وصوله إلى المحطة في 27 مارس 2015، قام بتفريغ شحنات من مركبات وشهد محاولتين فاشلتين للإمداد وشارك في العشرات من التجارب العلمية.
وقام كيلي أيضا بثلاث مهام للسير في الفضاء خارج المحطة التي تكلف إنشاؤها 100 مليار دولار، وتحلق على ارتفاع 400 كيلومتر من الأرض. وقال كيلي للصحفيين في آخر مؤتمر صحفي له على متن المحطة "حاولت تحقيق ذلك بإيقاع متعمد ولم أكن أترقب النهاية في الواقع، لكنني كنت أتطلع للإنجاز المقبل". وتابع "بوسعي أن أبقى 100 يوم وبمقدوري أن أظل هنا عاما آخر إذا اضطررت لذلك".

رائد الفضاء الأميركي سكوت كيلي
والفترة التي قضاها كيلي على متن المحطة وتصل إلى 340 يوما، تمثل نحو ضعف فترة أي مهمة فضائية أميركية سابقة، والهدف منها هو جمع معلومات طبية وهندسية استعدادا لرحلات إلى المريخ قد تستغرق ثلاث سنوات. وعقب عودته يخضع كيلي لفحوص طبية تستمر عدة أشهر فيما ينشغل شقيقه التوأم مارك كيلي وهو رائد فضاء سابق لدى إدارة الطيران والفضاء "ناسا" في سلسلة من الدراسات المتعلقة بنفس الموضوع، بحثا عن التغيرات الوراثية التي تطرأ على الإنسان جراء زيادة معدلات الإشعاع والتعرض لحالة انعدام الوزن في الفضاء.

إفريقيا البنفسجية

دائرة الكوارتز التي تكونت بسبب نشاط بركاني

الأرض الحديثة
بحيرة جنوبي آسيا

النور والظل في رقصة جميلة

الشمس تعكس نورها على صفائح أميركا وتظهرها كالذهب

الساحل الإسباني مزين بالألوان

قارة أستراليا

لوحة تكعيبية في الولايات المتحدة